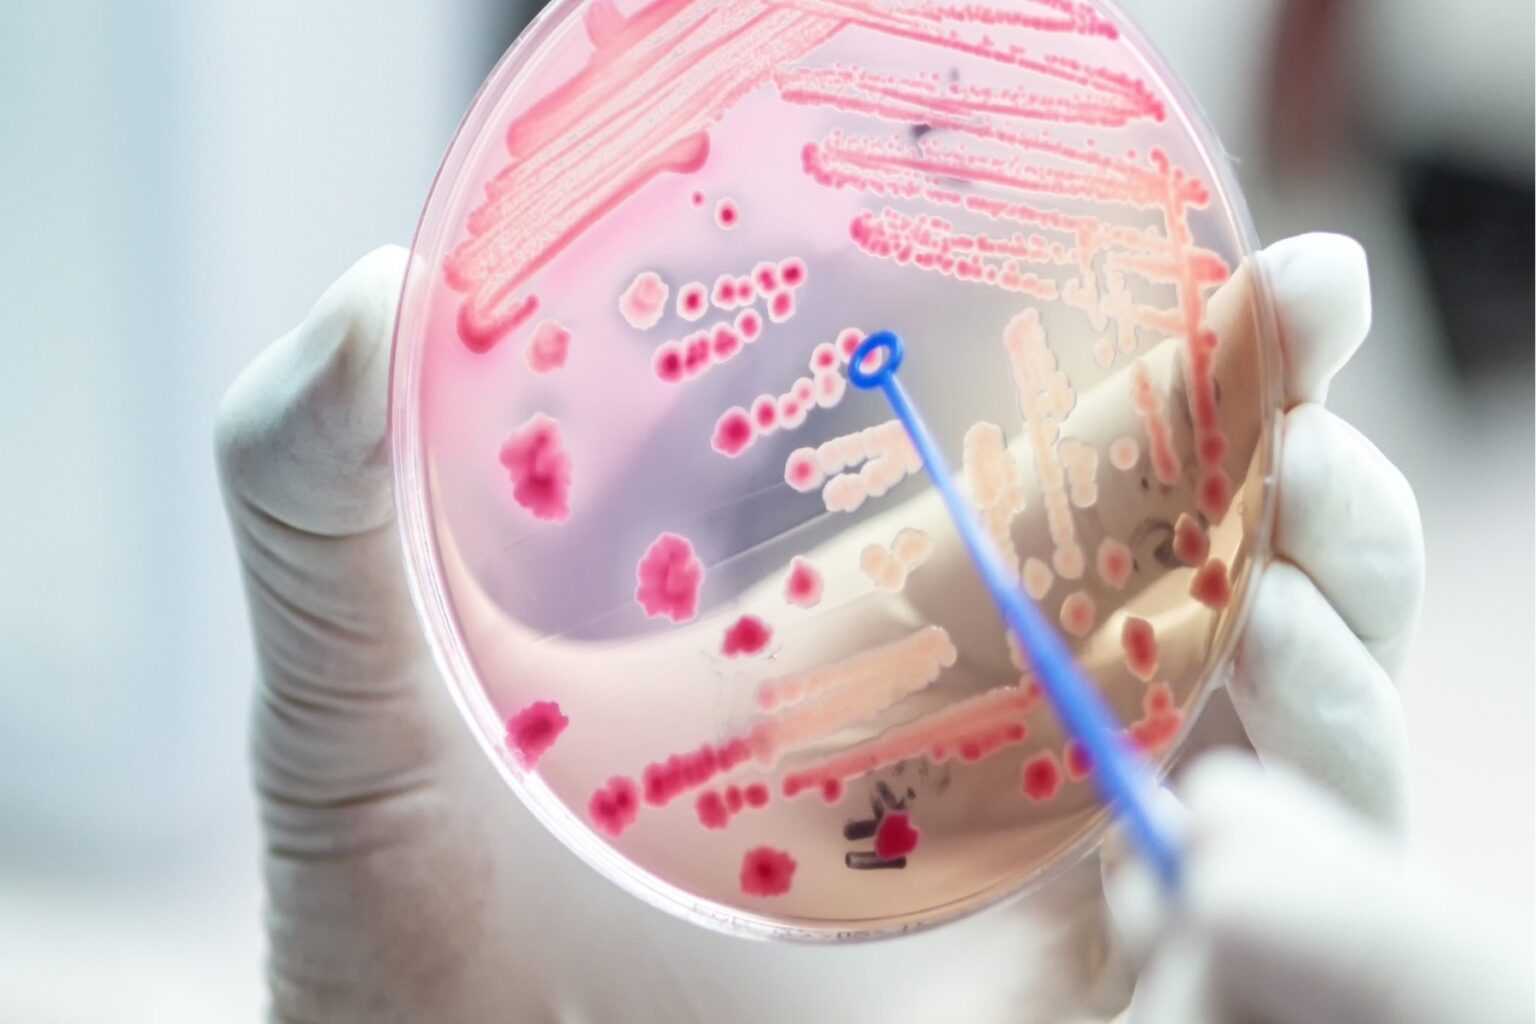

Αν και πολλοί άνθρωποι δεν το έχουν καν ακούσει, η σήψη είναι ο κύριος δολοφόνος των νοσηλευόμενων ασθενών στις Ηνωμένες Πολιτείες. Παγκοσμίως, η σήψη ευθύνεται για 1 στους 5 θανάτους κάθε χρόνο. Ακόμη και μεταξύ αυτών που θα επιβιώσουν, πολλοί δεν θα μπορέσουν ποτέ να επιστρέψουν στην εργασία τους και κάποιοι δεν θα μπορέσουν να επιστρέψουν στο σπίτι από το νοσοκομείο, απαιτώντας υποστήριξη ζωής ή συνεχή εντατική φροντίδα. Η σήψη είναι μια επείγουσα ιατρική κατάσταση που ξεκινά με μια λοίμωξη. Με την ανίχνευση βακτηρίων ή ιών, το σώμα σας απελευθερώνει έναν χορογραφημένο καταρράκτη χημικών ουσιών στην κυκλοφορία του αίματος. Αυτός ο χημικός συναγερμός καλεί ένα πυροβολικό κυττάρων του ανοσοποιητικού που εργάζονται από κοινού για να καταπολεμήσουν το ζωύφιο.

Όταν αυτό το σύστημα λειτουργεί καλά, το σώμα σας καθαρίζει τη μόλυνση και γίνεστε καλύτεροι. Αλλά όταν το σύστημα δεν λειτουργεί καλά, μπορεί να επέλθει σήψη. Η έναρξη της σήψης συμβαίνει όταν τα κύτταρα του ανοσοποιητικού σας στρέφονται από την καταπολέμηση της λοίμωξης στην καταπολέμηση των δικών σας ιστών και οργάνων. Αυτή η αντίδραση μπορεί να είναι παρόμοια με μια αυτοάνοση απόκριση, μια κατάσταση κατά την οποία το ανοσοποιητικό σύστημα του σώματος στρέφεται στον εαυτό του. Πολλοί άνθρωποι είναι εξοικειωμένοι με χρόνιες αυτοάνοσες ασθένειες όπως η ρευματοειδής αρθρίτιδα ή η νόσος του Crohn, αλλά μερικές φορές αυτός ο τύπος αυτοάνοσης απόκρισης μπορεί να εμφανιστεί ακόμη και σε υγιή άτομα.
Όταν εμφανίζεται σήψη, το ανοσοποιητικό σύστημα μπορεί συνήθως να τραυματίσει την καρδιά, τους πνεύμονες, τα νεφρά ή τα κύτταρα του αίματος, μεταξύ άλλων σημαντικών συστημάτων του σώματος. Η φλεγμονή στα αιμοφόρα αγγεία μπορεί να τα κάνει να διαρρέουν, προκαλώντας σοβαρή μείωση της ροής του αίματος στον εγκέφαλο και σε άλλα όργανα. Όταν συμβεί αυτό, η αρτηριακή πίεση ενός ατόμου μπορεί να μειωθεί επικίνδυνα, η οποία είναι μια σοβαρή μορφή σήψης γνωστή ως σηπτικό σοκ. Χωρίς έγκαιρη και κατάλληλη θεραπεία η σήψη μπορεί να προκαλέσει βλάβη οργάνων και ακόμη και θάνατο. Μόλις αναπτυχθεί το σοκ, η θνησιμότητα από σήψη εκτιμάται ότι θα αυξηθεί από το 10% στο 40%.
Η σήψη μπορεί να προκληθεί από σχεδόν οποιαδήποτε μόλυνση. Συχνότερα αναπτύσσεται από πνευμονία ή λοίμωξη του ουροποιητικού συστήματος. Ο σοβαρός COVID-19 μπορεί επίσης να προκαλέσει σήψη. Συχνά, οι ασθενείς με σήψη επισκέπτονται έναν ιατρό για συμπτώματα λοίμωξης την εβδομάδα που προηγείται της νοσηλείας της σήψης. Ωστόσο, είναι πολύ δύσκολο να προβλέψουμε ποιοι μολυσμένοι ασθενείς θα αναπτύξουν σήψη. Οι ακρογωνιαίοι λίθοι της θεραπείας της σήψης είναι η άμεση αναγνώριση των συμπτωμάτων της σήψης, ακολουθούμενη από αντιβιοτικά και υγρά. Αλλά ακόμη και οι πιο προσεκτικοί και προσεκτικοί γιατροί μπορούν να χάσουν τα πρώιμα σημάδια της σήψης. Αυτό οφείλεται σε μεγάλο βαθμό επειδή δεν υπάρχει ένα μόνο τεστ για τη θετική διάγνωση της σήψης. Τα συμπτώματα της σήψης μπορεί να μιμούνται άλλες απειλητικές για τη ζωή καταστάσεις, όπως καρδιακές προσβολές, θρόμβους αίματος, αιμορραγία ή ακόμα και αλλεργική αντίδραση.
Οι ασθενείς συχνά εμφανίζουν ασαφή και ποικίλα συμπτώματα όπως αδυναμία, ζαλάδα και γρήγορη αναπνοή, καθιστώντας τη διάγνωση ακόμη πιο δύσκολη. Για παράδειγμα, ένα νεαρό, κατά τα άλλα υγιές άτομο με σήψη λόγω πνευμονίας μπορεί να φαίνεται πολύ διαφορετικό από έναν ηλικιωμένο διαβητικό που αναπτύσσει σήψη από μια λοίμωξη του δέρματος που σιγοκαίει. Οι ασθενείς με σηψαιμία σχεδόν πάντα χρειάζονται εισαγωγή στο νοσοκομείο ή ακόμα και στη ΜΕΘ, και εκείνοι με σοβαρές μορφές σήψης συχνά χρειάζονται υποστήριξη ζωής. Αυτό μπορεί να περιλαμβάνει αιμοκάθαρση ή μηχανικό αερισμό για την υποστήριξη οργάνων που αποτυγχάνουν. Η πηγή μόλυνσης πρέπει να εντοπιστεί και, σε ορισμένες περιπτώσεις, να αφαιρεθεί χειρουργικά. Η καθυστέρηση της θεραπείας της σήψης έστω και για λίγες ώρες μπορεί να έχει θανατηφόρες συνέπειες.
Οι διαφορές στη σήψη υπερβαίνουν τα συμπτώματα. Η COVID-19 έχει αποκαλύψει ότι η σοβαρή ασθένεια δεν είναι τυχερό παιχνίδι. Όπως η μόλυνση από την COVID-19, η ευαισθησία στη σήψη —και ποιος είναι πιο πιθανό να αρρωστήσει και να πεθάνει— είναι μέρος μιας περίπλοκης αλληλεπίδρασης κοινωνικών επιρροών που περιλαμβάνουν ρατσισμό, φτώχεια, γεωγραφία και δυναμική της κοινότητας.